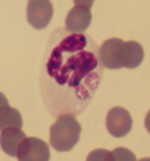
Anaplasma-morula Anaplasma-morula. Mikroskopbild.
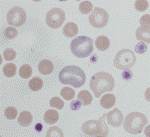
Sfärocyter Sfärocyter. Mikroskopbild.

Fakta:
Speciallaboratoriet för veterinärmedicinsk endokrinologi, klinisk kemi, hematologi och cytologi. Vi har Sveriges högsta veterinärmedicinska kompetens inom klinisk kemisk diagnostik.
Vid många hematologiska sjukdomstillstånd är manuell bedömning i mikroskop centralt för att kunna ställa rätt diagnos och ge djuret adekvat behandling. Vid misstanke om till exempel immunmedierad hemolytisk anemi, oxidativ förgiftning eller leukemi krävs mikroskopering för diagnos. Det förekommer att trombocyträkningen blir falskt låg vid analys i instrument och därför bör blodutstryk alltid kontrolleras vid misstanke om trombocytopeni.
Alla hematologiska prov som skickas till Klinisk kemiska laboratoriet vid SLU-Universitetsdjursjukhuset bedöms i mikroskop av erfaren laboratoriepersonal, samt analyseras med ett avancerat hematologiskt instrument, Advia 2120. Advia 2120 har olika program för olika djurslag och genererar många olika cellräkningar och cellkarakteristika, liksom plottar och diagram som ger värdefull information vid bedömningar av bland annat anemier och leukemier.
På Klinisk kemiska laboratoriet görs blodutstryk på alla hematologiska prover. De färgas med May Grünwald- Giemsa färg och bedöms i mikroskop av erfaren personal. Provet lämnas vid behov till veterinär med specialistkompetens i hematologisk diagnostik, som skriver en kommentar och ger information om hur provsvaret tolkas.
Vi gör även vissa kompletterande undersökningar utan extra kostnad när det är indicerat, exempelvis test för spontanagglutination vid misstanke om immunmedierad hemolytisk anemi och färgning för heinzkroppar vid misstanke om oxidativ förgiftning.
I bilden nedan ses två morula från Anaplasma phagocytophilum i cytoplasman hos en hundneutrofil. Oftast ses samtidigt trombocytopeni och lågt antal neutrofiler och lymfocyter.
I bilden nedan ses rikligt med sfärocyter (små mörka erytrocyter utan central uppklarning) i blodutstryk från en hund med immunmedierad hemolytisk anemi.
Speciallaboratoriet för veterinärmedicinsk endokrinologi, klinisk kemi, hematologi och cytologi. Vi har Sveriges högsta veterinärmedicinska kompetens inom klinisk kemisk diagnostik.
Öppettider: Vardagar kl. 08.00-16.10
Provmottagningen: tel. 018-67 16 23 (kl. 10-12, 13-16.10)
E-post: KlinKemLab@slu.se (ej akuta ärenden)
Veterinärkonsultation för remitterande veterinärer: tel. 018-67 16 19
Postadress:
Klinisk kemiska laboratoriet
Universitetsdjursjukhuset vid SLU
Box 7038
750 07 Uppsala